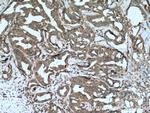
Cathepsin D Antibody in Immunohistochemistry (Paraffin) (IHC (P))
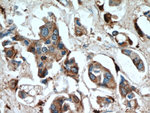
Cathepsin D Antibody in Immunohistochemistry (Paraffin) (IHC (P))
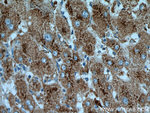
Cathepsin D Antibody in Immunohistochemistry (Paraffin) (IHC (P))

Search
Proteintech
Cathepsin D Polyclonal Antibody
{{$productOrderCtrl.translations['antibody.pdp.commerceCard.promotion.promotions']}}
{{$productOrderCtrl.translations['antibody.pdp.commerceCard.promotion.viewpromo']}}
{{$productOrderCtrl.translations['antibody.pdp.commerceCard.promotion.promocode']}}: {{promo.promoCode}} {{promo.promoTitle}} {{promo.promoDescription}}. {{$productOrderCtrl.translations['antibody.pdp.commerceCard.promotion.learnmore']}}
产品信息
21327-1-AP
种属反应
已发表种属
宿主/亚型
分类
类型
抗原
偶联物
形式
浓度
规格
纯化类型
保存液
内含物
保存条件
运输条件
产品详细信息
This antibody is specific to CTSD.
Immunogen sequence: VPAVTEGPI PEVLKNYMDA QYYGEIGIGT PPQCFTVVFD TGSSNLWVPS IHCKLLDIAC WIHHKYNSDK SSTYVKNGTS FDIHYGSGSL SGYLSQDTVS VPCQSASSAS ALGGVKVERQ VFGEATKQPG ITFIAAKFDG ILGMAYPRIS VNNVLPVFDN LMQQKLVDQN IFSFYLSRDP DAQPGGELML GGTDSKYYKG SLSYLNVTRK AYWQVHLDQV EVASGLTLCK EGCEAIVDTG TSLMVGPVDE VRELQKAIGA VPLIQGEYMI PCEKVSTLPA ITLKLGGKGY KLSPEDYTLK VSQAGKTLCL SGFMGMDIPP PSGPLWILGD VFIGRYYTVF DRDNNRVGFA EAARL (59-412 aa encoded by B C016320)
靶标信息
Cathepsin D is a gene located on chromosome 11p15.5 that encodes a lysosomal aspartic protease involved in the degradation of proteins. This enzyme is widely expressed in various tissues but is particularly abundant in the liver, kidneys, and brain, where it plays a crucial role in intracellular protein catabolism and turnover. Cathepsin D is synthesized as an inactive precursor, procathepsin D, which is activated in the acidic environment of lysosomes. Beyond its fundamental role in protein degradation, Cathepsin D has been implicated in several physiological and pathological processes, including apoptosis, hormone processing, and antigen presentation. Dysregulation of Cathepsin D expression or activity is associated with various diseases, such as neurodegenerative disorders, cancer, and cardiovascular diseases. In the context of cancer, Cathepsin D overexpression has been linked to tumor progression and metastasis, making it a potential biomarker and therapeutic target. Research continues to explore its diverse biological functions and therapeutic implications in various medical conditions.
仅用于科研。不用于诊断过程。未经明确授权不得转售。
生物信息学
蛋白别名: Cathepsin D; CathepsinD; Ceroid lipofuscinosis neuronal 10; ceroid-lipofuscinosis, neuronal 10; CTSD; epididymis secretory sperm binding protein Li 130P; lysosomal aspartyl peptidase; lysosomal aspartyl protease; MGC2311; OTTHUMP00000196039; OTTHUMP00000198692; preprocathepsin D
基因别名: CatD; CD; CLN10; CPSD; CTSD; HEL-S-130P
UniProt ID: (Human) P07339, (Mouse) P18242
Entrez Gene ID: (Human) 1509, (Mouse) 13033, (Rat) 171293